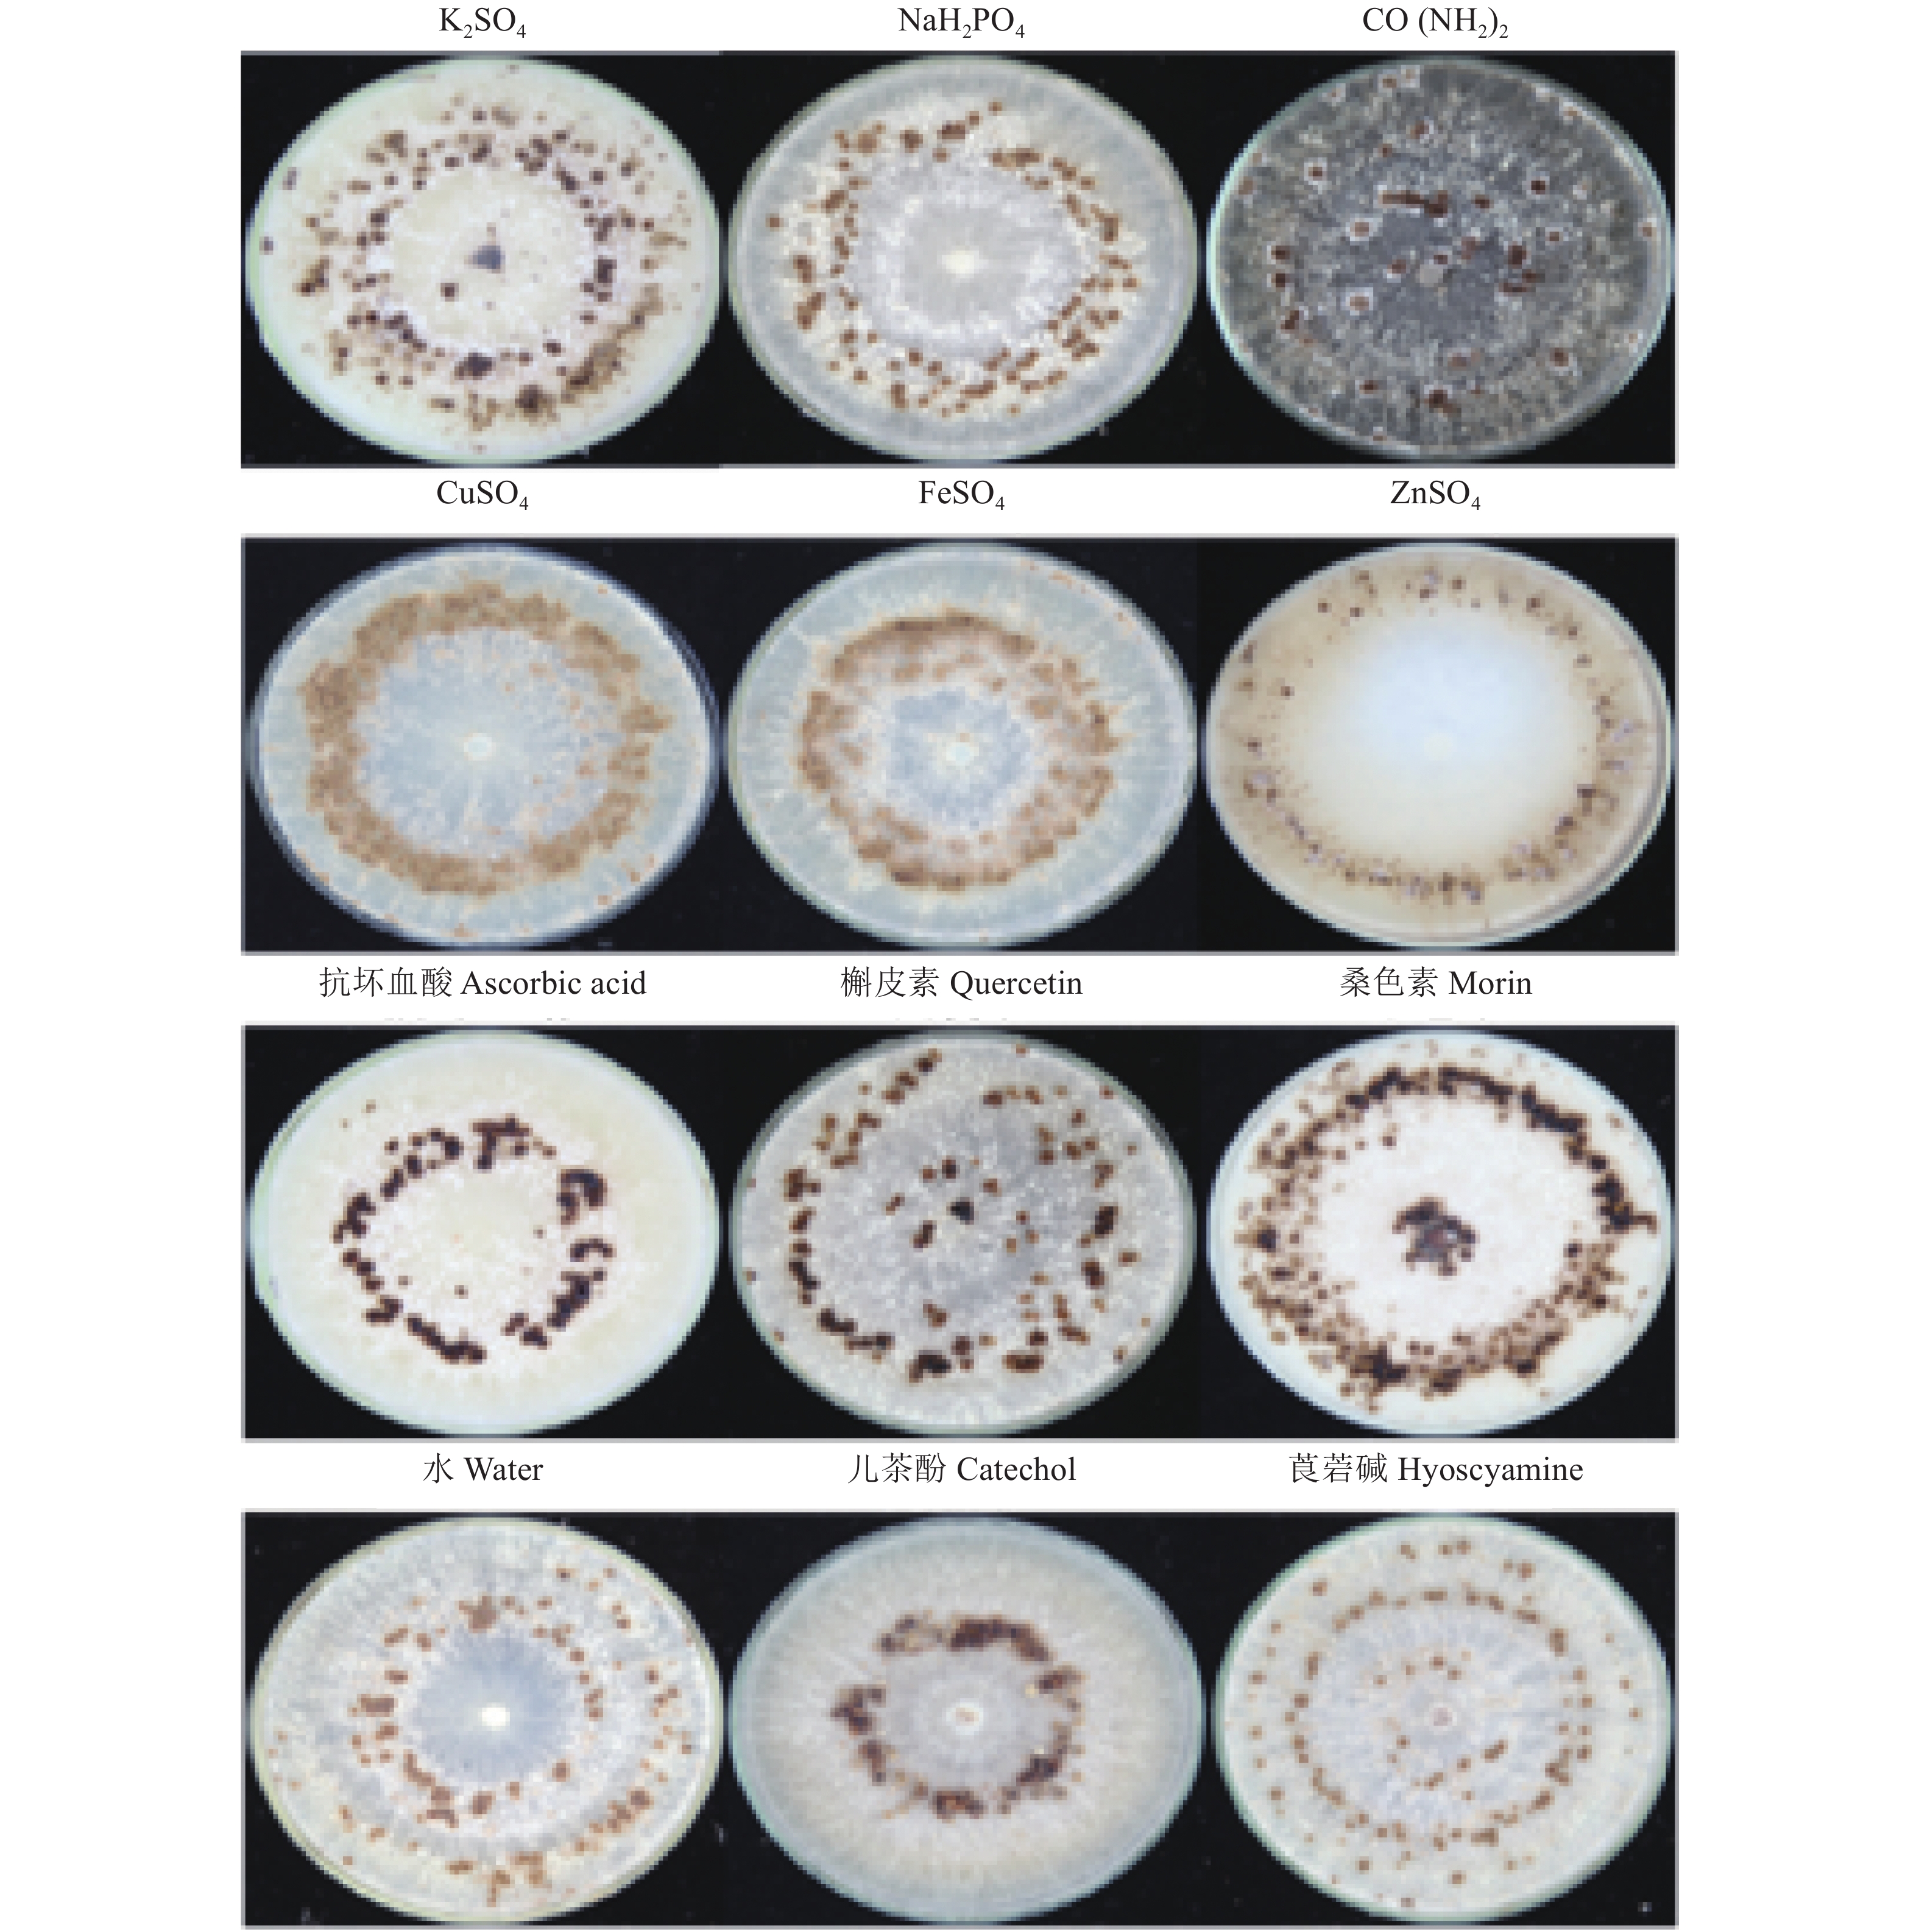

2. 桂林医学院 基础医学院,广西 桂林 541000
2. School of Basic Medical Sciences, Guilin Medical University, Guilin 541000, China
水稻纹枯病是由立枯丝核菌Rhizoctonia solaniAG-1 IA融合群引起的由土壤传播的植物病原真菌病害[1]。水稻纹枯病菌菌核的生长发育可以分为菌丝生长、菌核萌发和菌核的成熟黑化3个阶段[2]。黑色素广泛存在于动物、植物、真菌和细菌细胞中,是一种相对分子质量较大的化合物,多为非均质的多酚聚合体[3]。真菌黑色素是一种深褐色或黑色的色素,多存在于细胞壁中,具有抗氧化、抗紫外线、抵抗溶菌酶和寄主免疫攻击等生物学功能[4-5]。
水稻纹枯病菌主要以菌核的形式在土壤中越冬,而菌核中的黑色素能增强水稻纹枯病菌在不良环境下的生存能力,所以研究水稻纹枯病菌菌核以及黑色素发育机制有重要的理论和实际应用意义,但是国内外对菌核的研究主要集中于菌核发育方面,对水稻纹枯病菌菌丝生长和菌核发育机制以及黑色素形成的研究不多[6-8]。黑色素不仅能够增强菌丝和菌核在土壤中的生存能力,而且也是植物病原真菌重要的毒力因子[9-10]。因此,研究化学物质对水稻纹枯病菌黑色素形成的影响,有助于开发新型、高效的杀菌剂抑制水稻纹枯病菌的菌丝生长和菌核发育,从而达到防治水稻纹枯病的目的。
1 材料与方法 1.1 材料水稻纹枯病菌R. solani AG1-IA强致病力菌株GD-118[11]由广东省微生物信号与作物病害防控重点实验室提供。
马铃薯葡萄糖液体培养基(Potato dextrose broth, PDB)制备参考方中达[12]的方法。本研究使用的化学物质(表1)均为分析纯试剂,过滤除菌后制备不同浓度的母液,并进一步稀释使用,其浓度见表1。其中,莨菪碱为阴性对照,儿茶酚为阳性对照,水为空白对照。
|
|
表 1 本研究使用的化学物质及浓度 Table 1 Chemicals and concentrations used in this study |
水稻纹枯病菌GD-118菌株用PDA平板培养2 d后,用内径5.0 mm的打孔器在菌落边缘打取菌饼,置于培养基中央,将培养皿放在12 h光暗交替、28 ℃、相对湿度62 %的培养箱培养。以不加药剂的处理为空白对照,加入一定量的母液试剂配成所需使用浓度的PDA平板。
1.2.1 化学物质对水稻纹枯病菌菌丝生长速率和菌核形成的影响将供试菌株在PDA平板上培养2 d后,用内径5.0 mm的打孔器在菌落边缘打取菌饼,将菌饼移入含有不同药剂的PDA平板中央,28 ℃条件下黑暗培养24 h后,采用十字交叉法测量菌株的菌落直径,每个处理浓度重复3次;28 ℃条件下黑暗培养21 d,观察和记录菌株的菌核数量、大小、鲜质量和干质量,每个处理重复3次。
1.2.2 水稻纹枯病菌黑色素的提取和纯化水稻纹枯病菌菌核黑色素的提取和纯化参考Chen等[13]建立的方法。
1.2.3 紫外可见光谱分析称量水稻纹枯病菌黑色素2 mg,加少量1 mol/L NaOH(pH 8.0)溶解后,以ddH2O定容至50 mL,配成40 µg/mL黑色素溶液,进行紫外−可见光连续扫描(200~800 nm)。儿茶酚黑色素标准曲线设置:称量儿茶酚标准品4 mg,加1 mol/L NaOH(pH 8.0) 1 mL溶解后定容至50 mL,配成80 μg/mL黑色素溶液,稀释成0、10、20、40和80 μg/mL的黑色素溶液,利用紫外分光光度计(型号U-2910:日本HITACHI公司)测定D217 nm,并绘制出儿茶酚黑色素标准曲线(0~80 μg/mL),根据标准曲线计算出水稻纹枯病菌黑色素质量。
1.3 数据处理试验数据利用SPSS 19.0软件进行处理,采用Duncan’s法进行统计分析。
2 结果与分析 2.1 化学物质对水稻纹枯病菌菌丝生长和菌核质量的影响不同化学物质对水稻纹枯病菌的菌丝生长速率的影响结果见表2。由表2可以看出,在化学肥料组中,在含500 μg/mL K2SO4、NaH2PO4和CO(NH2)2的培养基上培养24 h后,水稻纹枯病菌菌丝生长速率差异显著,菌落直径表现为CO(NH2)2处理>K2SO4处理>NaH2PO4处理。与空白对照相比,500 μg/mL的NaH2PO4和K2SO4抑制水稻纹枯病菌菌丝生长,而500 μg/mL的CO(NH2)2促进水稻纹枯病菌菌丝生长。
|
|
表 2 化学物质对水稻纹枯病菌菌丝生长速率和菌核质量 (m) 的影响1) Table 2 Effects of chemicals on mycelial growth rate and sclerotial weight (m) of Rhizoctonia solani AG-1 IA |
在金属离子组中,在含有5 μg/mL CuSO4、ZnSO4和FeSO4的培养基上培养24 h后,水稻纹枯病菌菌丝生长速率差异显著,菌落直径表现为FeSO4处理>CuSO4处理>ZnSO4处理。与空白对照相比,5 μg/mL CuSO4和FeSO4能够促进水稻纹枯病菌菌丝的生长,而5 μg/mL的ZnSO4 抑制水稻纹枯病菌菌丝的生长。
在抗氧化剂组中,在含有5 μg/mL槲皮素、桑色素和抗坏血酸的培养基上培养24 h后,水稻纹枯病菌菌丝生长速率差异显著,菌落直径表现为抗坏血酸处理>槲皮素处理>桑色素处理。与空白对照相比,5 μg/mL的槲皮素和桑色素能够抑制水稻纹枯病菌菌丝的生长,而5 μg/mL抗坏血酸可以促进水稻纹枯病菌菌丝的生长。
在对照组中,相对于空白处理,300 μg/mL的莨菪碱促进水稻纹枯病菌菌丝的生长;而50 μg/mL的儿茶酚抑制水稻纹枯病菌菌丝的生长,不同对照处理间水稻纹枯病菌菌丝生长速率差异显著。
不同化学物质对水稻纹枯病菌菌核质量的影响结果见表2。由表2可见,在化学肥料组中,在含有500 μg/mL K2SO4、NaH2PO4和CO(NH2)2的培养基上培养21 d后,水稻纹枯病菌的菌核鲜质量和干质量均差异不显著。
在金属离子组中,在含有5 μg/mL CuSO4、ZnSO4和FeSO4的培养基上培养21 d后,FeSO4 处理的水稻纹枯病菌菌核鲜质量和干质量均显著高于CuSO4、ZnSO4处理的,但CuSO4和ZnSO4处理间的水稻纹枯病菌菌核鲜质量和干质量差异不显著。
在抗氧化剂组中,在含有5 μg/mL槲皮素、桑色素和抗坏血酸的培养基上培养21 d后,桑色素处理的水稻纹枯病菌菌核鲜质量和干质量均显著高于槲皮素和抗坏血酸处理的,但槲皮素和抗坏血酸处理间的水稻纹枯病菌菌核鲜质量和干质量差异不显著。
在对照组中,在含有300 μg/mL莨菪碱、50 μg/mL儿茶酚培养基上培养21 d后,与空白对照相比,水稻纹枯病菌菌核鲜质量和干质量没有显著差异。
2.2 化学物质对水稻纹枯病菌菌核形态和分布以及菌核数量的影响不同化学物质对水稻纹枯病菌菌核形态和分布以及数量的影响结果如图1、图2所示。
|
图 1 不同化学物质处理的水稻纹枯病菌菌核形态及分布 Fig. 1 Morphology and distribution of sclerotia of Rhizoctonia solani AG-1 IA treated by different chemicals |

|
图 2 不同化学物质对水稻纹枯病菌菌核数量的影响 Fig. 2 Effects of different chemicals on sclerotia numbers of Rhizoctonia solaniAG-1 IA 相同图标的柱子上的不同小写字母表示差异显著(P<0.05,Duncan’s法) Different lowercase letters on pillars of the same icon indicate significant differences (P<0.05,Duncan’s test) |
在化学肥料组中,水稻纹枯病菌在含有500 μg/mL K2SO4、NaH2PO4和CO(NH2)2的培养基上培养21 d后,菌核形态分布有明显的差异(图1)。其中,CO(NH2)2和NaH2PO4 促进水稻纹枯病菌菌核的产生,菌核数量增多。CO(NH2)2 菌核数量最多,每个培养皿平均产生94个菌核(图2),同时也可以明显观察到水稻纹枯病菌菌丝的褐化甚至黑化现象,并分泌黑色素到PDA培养基中(图1)。K2SO4 溶液菌核数量最少,每个培养皿中平均只能产生73个菌核(图2),明显抑制菌核的产生。
在金属离子组中,水稻纹枯病菌在含有5 μg/mL CuSO4、ZnSO4和FeSO4的培养基上培养21 d后,CuSO4和FeSO4促进水稻纹枯病菌菌核的产生,菌核数量增多,但与空白对照相比差异不显著,每个培养皿平均能产生90个以上的菌核,而ZnSO4菌核数量最少,每个培养皿平均只能产生70个菌核,抑制水稻纹枯病菌菌核的增加,与CuSO4和FeSO4处理相比,都有显著差异(图2)。
在抗氧化剂组中,水稻纹枯病菌在含有5 μg/mL槲皮素、桑色素和抗坏血酸的培养基上培养21 d后,菌核形态分布有较大差异(图1)。从图2可以看出,槲皮素、桑色素和抗坏血酸处理的水稻纹枯病菌菌核数量有显著差异。槲皮素和桑色素能促进菌核的产生,菌核数量增多,其中,桑色素溶液菌核数量最多,每个培养皿中平均能产生93个菌核,抗坏血酸溶液菌核数量最少,每个培养皿平均只能产生70个菌核。
在对照组中,在含有300 μg/mL的莨菪碱、50 μg/mL儿茶酚和空白对照的培养基上培养21 d后,水稻纹枯病菌菌核形态分布有明显的差异,结果见图1。各对照的水稻纹枯病菌菌核数量存在显著差异,其中,莨菪碱促进菌核数量的增加,每个培养皿平均产生88个菌核,儿茶酚显著抑制菌核数量的增加,每个培养皿平均只能产生47个菌核,而空白对照每个培养皿平均能产生77个菌核(图2)。
2.3 化学物质对水稻纹枯病菌黑色素产生的影响利用紫外−可见光谱对水稻纹枯病菌黑色素进行分析,发现吸光度随波长的增大而减小,在217 nm处有明显的强吸收峰,即为水稻纹枯病菌黑色素的特征吸收峰(图3)。测定不同质量浓度的儿茶酚黑色素的D217 nm,并进行回归分析,得到回归方程:y=0.018 0x−0.018 3,R2=0.997 7。结果表明儿茶酚黑色素质量浓度与紫外吸光度有良好的线性关系。将培养21 d的10 g菌核充分干燥研磨成粉末状后提取和纯化黑色素,测定其质量,结果列于表3。

|
图 3 水稻纹枯病菌黑色素的紫外−可见光吸收光谱 Fig. 3 Ultraviolet-visible light absorption spectra of the melanin of Rhizoctonia solani AG-1 IA |
|
|
表 3 化学物质对水稻纹枯病菌黑色素产生的影响 Table 3 Effects of chemicals on the melanin formation of Rhizoctonia solani AG-1 IA |
由表3可见,在化学肥料组中,与空白对照相比,500 μg/mL K2SO4、NaH2PO4和CO(NH2)2促进水稻纹枯病菌菌核黑色素的形成,产生黑色素的质量排序为CO(NH2)2)>NaH2PO4>K2SO4。
在金属离子组中,与空白对照相比,5 μg/mLCuSO4和ZnSO4促进水稻纹枯病菌菌核黑色素的形成,5 μg/mL FeSO4抑制水稻纹枯病菌菌核黑色素的形成,产生黑色素的质量排序为CuSO4>ZnSO4>FeSO4。
在抗氧化剂组中,与空白对照相比,5 μg/mL槲皮素、桑色素和抗坏血酸均能促进水稻纹枯病菌菌核黑色素的形成,产生黑色素的质量排序为桑色素>槲皮素>抗坏血酸。
在对照组中,与空白对照相比,莨菪碱抑制水稻纹枯病菌菌核黑色素的形成,儿茶酚促进水稻纹枯病菌菌核黑色素的形成。
3 结论与讨论田间施用化学肥料对水稻纹枯病的影响已有较多研究。氮、磷、钾肥是水稻增产必不可少的肥料,其含量也影响着水稻纹枯病菌的生长发育。Moromizato等[14]发现钾对水稻纹枯病病菌菌核形成的最适质量浓度为100 μg/mL。本研究中,500 μg/mL的K2SO4和NaH2PO4能抑制水稻纹枯病菌丝的生长发育,但NaH2PO4能促进水稻纹枯病菌菌核数量的增多,而这有利于水稻纹枯病菌休眠体菌核的形成与传播;500 μg/mL的CO(NH2)2既促进了水稻纹枯病菌菌丝的生长,也使得菌核数量增加,说明氮肥的大量使用可能会造成水稻纹枯病的暴发,与沈会芳等[15]的研究结果一致。
在农业集约化的耕作模式下,土壤中的金属离子会和植物病原菌发生协同或拮抗作用,直接或者间接地影响病原菌的生长、繁殖以及致病力等,从而对病害传播产生一定影响。刘力等[16]研究表明立枯丝核菌不同融合群对微量元素的相对敏感性不同。Englander等[17]研究了Cu2+等17种金属离子对栗疫病菌Cryphonectria parasitic生长发育的影响;刘杏忠等[18]报道了Hg2+等6种重金属离子对多种水霉的毒性。沈会芳等[19]发现Cu2+、Zn2+和Fe2+能够影响水稻纹枯病菌的菌丝干质量,且在含有5 μg/mL Cu2+、Zn2+和Fe2+的PDA中,水稻纹枯病菌菌丝质量有所增加。在本研究中发现5 μg/mL的CuSO4和FeSO4能促进水稻纹枯病菌菌丝的生长发育,同时也促进菌核数量的增加;而5 μg/mL的ZnSO4溶液抑制水稻纹枯病菌菌丝生长发育,同时也抑制了水稻纹枯病菌菌核数量的增加,结果对于防治水稻纹枯病具有参考意义。
微生物细胞分化的因素包括不稳定的超氧状态,它能够诱导并促进自身分化[17, 20]。Georgiou等[21]研究表明植物病原真菌在菌核分化过程中会产生脂质氧化物,并对氧化应激诱导的菌核分化机制提出了假说,根据该假说通过增加抗氧化剂可以降低氧化胁迫的作用,进而对菌核的生长发育产生影响。例如齐整小核菌Sclerotium rolfsii的菌核形成常常伴随着脂质氧化,菌核是由活性氧引起的氧化应激诱导产生的[22]。对槲皮素、桑色素等抗氧化剂对水稻纹枯病菌菌核的形成影响进行研究,结果发现不同浓度的抗氧化剂能够影响水稻纹枯病菌菌核的形成以及世代时间,并且在5 μg/mL槲皮素和桑色素诱导下,水稻纹枯病菌菌核质量明显增多,但是世代时间较为稳定[23]。张传玉等[24]试验表明抗坏血酸可以消除氧化胁迫对不同水稻品种造成的伤害,进而提高水稻的抗逆能力。目前少数植物病原真菌的菌核形成机制比较清楚,而菌核分化可能是真菌抗氧化调节形成的,抗坏血酸作为抗氧化剂通过调节脂质过氧化水平,影响菌核发育阶段的分化能力[25]。本研究结果表明,5 μg/mL槲皮素和桑色素抑制水稻纹枯病菌菌丝生长的同时使得菌核数量增多,有利于水稻纹枯病菌的传播;而5 μg/mL的抗坏血酸恰好相反,促进水稻纹枯病菌菌丝生长发育的同时抑制水稻纹枯病菌菌核数量的增加,可用来防止水稻纹枯病病菌的扩散蔓延。
Abdel-motaal等[26]的研究表明,对于稻瘟病菌和立枯丝核菌,l μg/mL的莨菪碱会引起菌丝体电解质的泄漏,延缓或抑制真菌孢子萌发和附着胞的形成,并且结果不可逆转;400 μg/mL莨菪碱处理时,稻瘟病菌附着胞的死亡率约为10%,1 000 μg/mL莨菪碱处理时,附着胞的死亡率约为70%。儿茶酚作为一种抗氧化剂,不仅能抗衰老,同时还具有非常好的抗真菌效果。本研究中,300 μg/mL的莨菪碱能够促进水稻纹枯病菌菌丝生长和菌核的增加,而50 μg/mL儿茶酚溶液抑制水稻纹枯病菌菌丝生长的同时抑制水稻纹枯病菌菌核数量的增加。儿茶酚和莨菪碱对水稻纹枯病菌菌核黑白表型的影响非常明显。
本研究中,500 μg/mL K2SO4、NaH2PO4和CO(NH2)2处理能有效促进水稻纹枯病菌黑色素的生成,从而增强水稻纹枯病菌的抗逆性,增强其对不良环境的适应性,特别是CO(NH2)2处理。大量施用氮肥容易加重水稻纹枯病的病害程度,反映出在实际耕作中,氮肥使用量不宜过多。5 μg/mL的CuSO4和ZnSO4处理有利于黑色素的形成,而5 μg/mL的CuSO4处理虽然菌核质量减少,但数量增多;5 μg/mL的ZnSO4处理不仅抑制水稻纹枯病菌菌丝的生长发育,同时也抑制水稻纹枯病菌菌核数量和质量的增加,说明ZnSO4对水稻纹枯病菌的抑制作用强于CuSO4。当水稻纹枯病菌菌体受到金属离子胁迫时,由于自身保护作用,反而促进水稻纹枯病菌黑色素的分泌,增强其对外界不良环境的抗逆性,而5 μg/mL的FeSO4处理能促进水稻纹枯病菌菌核数量的增加,但对黑色素的形成有抑制作用,降低了水稻纹枯病菌对环境的适应能力。5 μg/mL抗坏血酸能抑制水稻纹枯病菌菌核数量的增长,但却促进水稻纹枯病菌菌核黑色素的形成,而5 μg/mL槲皮素、桑色素能促进水稻纹枯病菌菌核数量的增加,有利于水稻纹枯病菌的传播,并且促进水稻纹枯病菌菌核黑色素的形成,可以提高水稻纹枯病菌抗逆能力。300 μg/mL莨菪碱能促进水稻纹枯病菌菌丝生长和菌核数量增加,但是抑制黑色素的形成;而50 μg/mL的儿茶酚不仅抑制水稻纹枯病菌菌丝生长,也抑制水稻纹枯病菌菌核数量的增加,但可以促进水稻纹枯病菌黑色素的形成。
本研究结果表明不同化学物质对水稻纹枯病菌菌丝的生长速率、菌核数量、菌核大小、菌核鲜质量和干质量以及黑色素产生的影响程度不同。抑制水稻纹枯病菌菌丝和菌核生长发育的化学物质,不一定抑制水稻纹枯病菌菌核生长发育。500 μg/mL K2SO4、NaH2PO4和CO (NH2)2,5 μg/mL CuSO4和ZnSO4,5 μg/mL槲皮素、桑色素和抗坏血酸以及50 μg/mL的儿茶酚溶液对黑色素的形成均有促进作用,而5 μg/mL FeSO4和300 μg/mL莨菪碱处理对黑色素形成有抑制作用,这为水稻纹枯病菌在不同环境中的适应性提供了理论依据。
| [1] |
ELAD Y. The use of antioxidants (free radical scavengers) to control grey mould (Botrytis cinerea) and white mould (Sclerotinia sclerotiomm) in various crops
[J]. Plant Pathol, 1992, 41(4): 417-426. DOI:10.1111/j.1365-3059.1992.tb02436.x (  0) 0) |
| [2] |
TOWNSEND B B. Nutritional factors influencing the production of sclerotia by certain fungi[J]. Ann Bot, 1957, 21(81): 153-166. (  0) 0) |
| [3] |
曹志艳, 杨胜勇, 董金皋. 植物病原真菌黑色素与致病性关系的研究进展[J]. 微生物学通报, 2006, 33(1): 154-158. DOI:10.3969/j.issn.0253-2654.2006.01.031 (  0) 0) |
| [4] |
REVANKAR S G, SUTTON D A. Melanized fungi in human disease[J]. Clin Microbiol Rev, 2010, 23(4): 884. DOI:10.1128/CMR.00019-10 (  0) 0) |
| [5] |
江绍锋, 王陈骄子, 舒灿伟, 等. 水稻纹枯病菌RsCat基因的克隆及其表达分析
[J]. 华中农业大学学报, 2018, 37(3): 25-31. (  0) 0) |
| [6] |
BELOZERSKAYA T A, GESSLER N N, AVER YANOV A A. Melanin pigments of fungi[M]. Berlin: Springer International Publishing, 2015.
(  0) 0) |
| [7] |
MISHRA S, SINGH H B. Silver nanoparticles mediated altered gene expression of melanin biosynthesis genes in Bipolaris sorokiniana
[J]. Microbiol Res, 2015, 172(64): 16-18. (  0) 0) |
| [8] |
JIANG S, WANG C, SHU C, et al. Effects of catechol on growth, antioxidant enzyme activities and melanin biosynthesis gene expression of Rhizoctonia solani AG-1 IA
[J]. Can J Plant Pathol, 2018, 40(2): 220-228. DOI:10.1080/07060661.2018.1437775 (  0) 0) |
| [9] |
FENG B, WANG X, HAUSER M, et al. Molecular cloning and characterization of WdPKS1, a gene involved in dihydroxynaphthalene melanin biosynthesis and virulence in Wangiella(Exophiala) dermatitidis
[J]. Infect Immun, 2001, 69(3): 1781. DOI:10.1128/IAI.69.3.1781-1794.2001 (  0) 0) |
| [10] |
江绍锋, 王陈骄子, 舒灿伟, 等. 水稻纹枯病菌RsPhm基因的克隆及其表达分析
[J]. 中国水稻科学, 2018, 32(2): 111-118. (  0) 0) |
| [11] |
YANG Y Q, YANG M, LI M H, et al. Cloning and functional analysis of an endo-PG-encoding gene Rrspg1 of Rhizoctonia solani, the causal agent of rice sheath blight
[J]. Can J Plant Pathol, 2012, 34(3): 436-447. DOI:10.1080/07060661.2012.709884 (  0) 0) |
| [12] |
方中达. 植病研究方法[M]. 3版. 北京: 中国农业出版社, 1998: 46.
(  0) 0) |
| [13] |
CHEN J, WANG C, SHU C, et al. Isolation and characterization of a melanin from Rhizoctonia solani, the causal agent of rice sheath blight
[J]. Eur J Plant Pathol, 2015, 142(2): 281-290. DOI:10.1007/s10658-015-0612-0 (  0) 0) |
| [14] |
MOROMIZATO Z, MATSUYAMA N, WAKIMOTO S. The effect of amino acids on sclerotium formation of Rhizoctonia solani Kühn (AG-1) I: Inhibition of sclerotial formation by various amino acids
[J]. Jap J Plant Pathol, 1980, 46(1): 15-20. (  0) 0) |
| [15] |
沈会芳, 周而勋, 戚佩坤. 化学肥料对水稻纹枯病菌菌丝生长和菌核形成的影响[J]. 华南农业大学学报, 2002, 23(2): 94. DOI:10.3969/j.issn.1001-411X.2002.02.029 (  0) 0) |
| [16] |
刘力, 葛起新. 立枯丝核菌融合群对四种微量元素敏感性的研究[J]. 植物病理学报, 1988, 18(3): 175-178. (  0) 0) |
| [17] |
ENGLANDER C M, CORDEN M E. Stimulation of mycelial growth of Endothia parasitica by heavy metals
[J]. Appl Microbiol, 1971, 22(6): 1012-1016. DOI:10.1128/AEM.22.6.1012-1016.1971 (  0) 0) |
| [18] |
刘杏忠, 沈崇尧, 裘维蕃. 重金属离子对一些水霉的毒性[J]. 植物病理学报, 1989, 19(3): 173-177. DOI:10.3321/j.issn:0412-0914.1989.03.002 (  0) 0) |
| [19] |
沈会芳, 周而勋, 戚佩坤. 金属离子对水稻纹枯病菌菌丝生长和菌核形成的影响[J]. 华南农业大学学报, 2002, 23(1): 38-40. DOI:10.3969/j.issn.1001-411X.2002.01.011 (  0) 0) |
| [20] |
WANG C, PI L, JIANG S, et al. ROS and trehalose regulate sclerotial development in Rhizoctonia solani AG-1 IA
[J]. Fungal Biol, 2018, 122(5): 322-332. DOI:10.1016/j.funbio.2018.02.003 (  0) 0) |
| [21] |
GEORGIOU C D, ZEES A. Lipofuscins and sclerotial differentiation in phytopathogenic fungi[J]. Mycopathologia, 2002, 153(4): 203-208. DOI:10.1023/A:1014988419357 (  0) 0) |
| [22] |
GEORGIOU C D. Lipid peroxidation in Sclerotium rolfsii: A new look into the mechanism of sclerotial biogenesis in fungi
[J]. Mycol Res, 1997, 101(4): 460-464. DOI:10.1017/S0953756296002882 (  0) 0) |
| [23] |
LU L, SHU C, LIU C, et al. The impacts of natural antioxidants on sclerotial differentiation and development in Rhizoctonia solani AG-1 IA
[J]. Eur J Plant Pathol, 2016, 146(4): 729-740. DOI:10.1007/s10658-016-0953-3 (  0) 0) |
| [24] |
张传玉, 张执金, 黄荣峰, 等. 水稻品种中VC含量及抗氧化性的比较分析[J]. 中国农业科技导报, 2011, 13(6): 6-11. DOI:10.3969/j.issn.1008-0864.2011.06.02 (  0) 0) |
| [25] |
GEORGIOU C D, ZERVOUDAKIS G, PETROPOULOU K P. Ascorbic acid might play a role in the sclerotial differentiation of Sclerotium rolfsii
[J]. Mycologia, 2003, 95(2): 308-316. DOI:10.1080/15572536.2004.11833115 (  0) 0) |
| [26] |
ABDEL-MOTAAL F F, EL-ZAYAT S A, KOSAKA Y, et al. Antifungal activities of hyoscyamine and scopolamine against two major rice pathogens: Magnaporthe oryzae and Rhizoctonia solani
[J]. J Gen Plant Pathol, 2010, 76(2): 102-111. DOI:10.1007/s10327-010-0225-6 (  0) 0) |
 2020, Vol. 41
2020, Vol. 41


